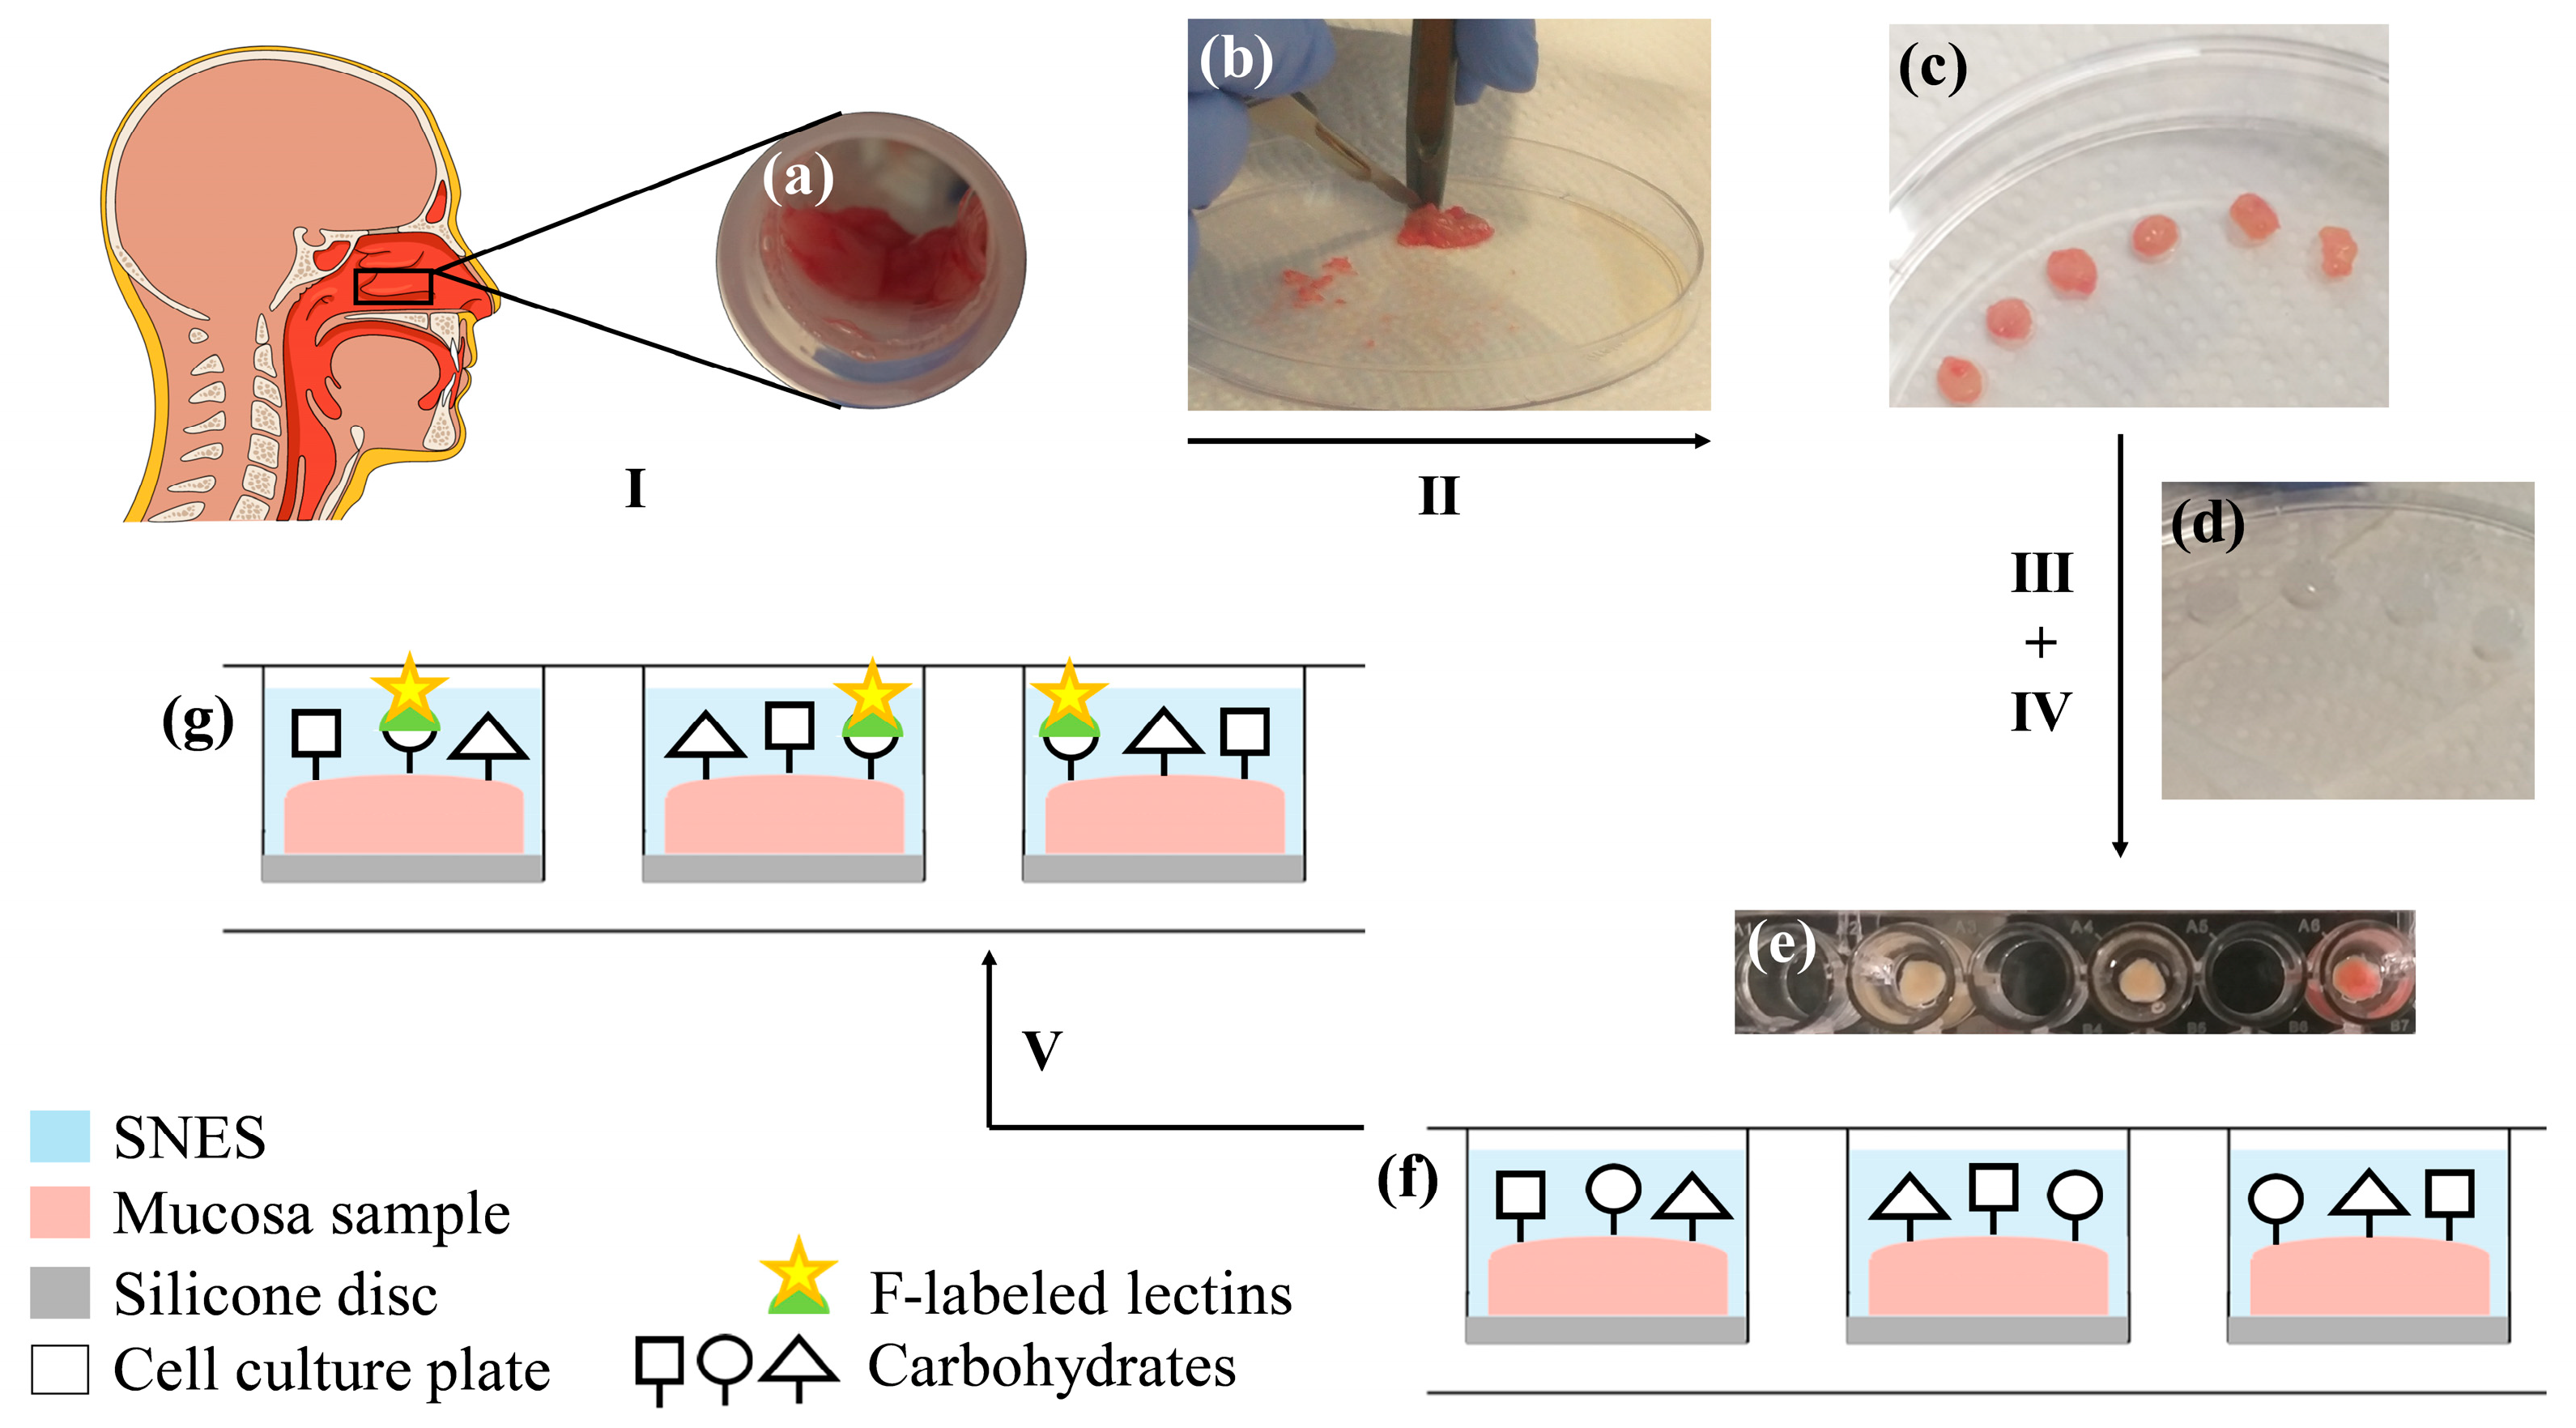
Pharmaceutics 15 00973 g001

A Novel Preparation Technique for Human Nasal Respiratory Mucosa to Disclose Its Glycosylation Pattern for Bioadhesive Drug Delivery
Abstract
1. Introduction
2. Materials and Methods
2.1. Materials
2.2. Preparation of Human Nasal Mucosa Samples and Experimental Setup
2.3. Fluorimetric Quantification of the Lectin Binding Capacity of the Human Nasal Mucosa
2.4. Microscopical Evaluation of Lectin Binding
2.5. Calculations
2.6. Statistical Analysis
3. Results and Discussion
3.1. Considerations for the Experimental Setup
3.2. Lectin Binding Studies
3.3. Microscopical Visualisation of Lectin Binding Capacities
3.4. Internalisation and (Intra)Cellular Fate of Lectins
3.5. Interplay between the Mucus Layer and Cell Association
4. Conclusions
Supplementary Materials
Author Contributions
Funding
Institutional Review Board Statement
Informed Consent Statement
Data Availability Statement
Conflicts of Interest
References
- Goldstein, I.J.; Hayes, C.E. The lectins: Carbohydrate-binding proteins of plants and animals. Adv. Carbohydr. Chem. Biochem. 1978, 35, 127–340. [Google Scholar] [CrossRef]
- Lis, H.; Sharon, N. CHAPTER 7—Lectins: Their Chemistry and Application to Immunology. In The Antigens; Sela, M., Ed.; Academic Press: Cambridge, MA, USA, 1977; pp. 429–529. [Google Scholar] [CrossRef]
- Uchimido, R.; Schmidt, E.P.; Shapiro, N.I. The glycocalyx: A novel diagnostic and therapeutic target in sepsis. Crit. Care 2019, 23, 16. [Google Scholar] [CrossRef]
- Verhelst, X.; Dias, A.M.; Colombel, J.-F.; Vermeire, S.; Van Vlierberghe, H.; Callewaert, N.; Pinho, S.S. Protein Glycosylation as a Diagnostic and Prognostic Marker of Chronic Inflammatory Gastrointestinal and Liver Diseases. Gastroenterology 2020, 158, 95–110. [Google Scholar] [CrossRef]
- Kolářová, H.; Ambrůzová, B.; Šindlerová, L.Š.; Klinke, A.; Kubala, L. Modulation of Endothelial Glycocalyx Structure under Inflammatory Conditions. Mediat. Inflamm. 2014, 2014, 694312. [Google Scholar] [CrossRef] [PubMed]
- Munkley, J.; Elliott, D.J. Hallmarks of glycosylation in cancer. Oncotarget 2016, 7, 35478–35489. [Google Scholar] [CrossRef] [PubMed]
- Buffone, A.; Weaver, V.M. Don’t sugarcoat it: How glycocalyx composition influences cancer progression. J. Cell Biol. 2020, 219, e201910070. [Google Scholar] [CrossRef] [PubMed]
- Kang, H.; Wu, Q.; Sun, A.; Liu, X.; Fan, Y.; Deng, X. Cancer Cell Glycocalyx and Its Significance in Cancer Progression. Int. J. Mol. Sci. 2018, 19, 2484. [Google Scholar] [CrossRef]
- von Palubitzki, L.; Wang, Y.; Hoffmann, S.; Vidal-y-Sy, S.; Zobiak, B.; Failla, A.V.; Schmage, P.; John, A.; Osorio-Madrazo, A.; Bauer, A.T.; et al. Differences of the tumour cell glycocalyx affect binding of capsaicin-loaded chitosan nanocapsules. Sci. Rep. 2020, 10, 22443. [Google Scholar] [CrossRef]
- Apfelthaler, C.; Gassenbauer, P.; Weisse, S.; Gabor, F.; Wirth, M. A lectin mediated delivery system for the intravesical treatment of bladder diseases using poly-(L)-glutamic acid as polymeric backbone. Eur. J. Pharm. Sci. Off. J. Eur. Fed. Pharm. Sci. 2018, 111, 376–382. [Google Scholar] [CrossRef]
- Apfelthaler, C.; Anzengruber, M.; Gabor, F.; Wirth, M. Poly-(l)-glutamic acid drug delivery system for the intravesical therapy of bladder cancer using WGA as targeting moiety. Eur. J. Pharm. Biopharm. Off. J. Arb. Fur Pharm. Verfahr. E.V 2017, 115, 131–139. [Google Scholar] [CrossRef]
- Diesner, S.C.; Wang, X.-Y.; Jensen-Jarolim, E.; Untersmayr, E.; Gabor, F. Use of lectin-functionalized particles for oral immunotherapy. Ther. Deliv. 2012, 3, 277–290. [Google Scholar] [CrossRef] [PubMed]
- Brück, A.; Abu-Dahab, R.; Borchard, G.; Schäfer, U.F.; Lehr, C.M. Lectin-functionalized liposomes for pulmonary drug delivery: Interaction with human alveolar epithelial cells. J. Drug Target. 2001, 9, 241–251. [Google Scholar] [CrossRef] [PubMed]
- Sharma, A.; Sharma, S.; Khuller, G.K. Lectin-functionalized poly (lactide-co-glycolide) nanoparticles as oral/aerosolized antitubercular drug carriers for treatment of tuberculosis. J. Antimicrob. Chemother. 2004, 54, 761–766. [Google Scholar] [CrossRef] [PubMed]
- Rodrigues, J.S.; Santos-Magalhães, N.S.; Coelho, L.C.B.B.; Couvreur, P.; Ponchel, G.; Gref, R. Novel core(polyester)-shell(polysaccharide) nanoparticles: Protein loading and surface modification with lectins. J. Control. Release 2003, 92, 103–112. [Google Scholar] [CrossRef]
- Engleder, E.; Demmerer, E.; Wang, X.; Honeder, C.; Zhu, C.; Studenik, C.; Wirth, M.; Arnoldner, C.; Gabor, F. Determination of the glycosylation-pattern of the middle ear mucosa in guinea pigs. Int. J. Pharm. 2015, 484, 124–130. [Google Scholar] [CrossRef]
- Neutsch, L.; Wambacher, M.; Wirth, E.-M.; Spijker, S.; Kählig, H.; Wirth, M.; Gabor, F. UPEC biomimickry at the urothelial barrier: Lectin-functionalized PLGA microparticles for improved intravesical chemotherapy. Int. J. Pharm. 2013, 450, 163–176. [Google Scholar] [CrossRef]
- Gabor, F.; Stangl, M.; Wirth, M. Lectin-mediated bioadhesion: Binding characteristics of plant lectins on the enterocyte-like cell lines Caco-2, HT-29 and HCT-8. J. Control. Release 1998, 55, 131–142. [Google Scholar] [CrossRef]
- Soane, R.J.; Frier, M.; Perkins, A.C.; Jones, N.S.; Davis, S.S.; Illum, L. Evaluation of the clearance characteristics of bioadhesive systems in humans. Int. J. Pharm. 1999, 178, 55–65. [Google Scholar] [CrossRef]
- Ugwoke, M.I.; Agu, R.U.; Verbeke, N.; Kinget, R. Nasal mucoadhesive drug delivery: Background, applications, trends and future perspectives. Adv. Drug Deliv. Rev. 2005, 57, 1640–1665. [Google Scholar] [CrossRef]
- Djupesland, P.G. Nasal drug delivery devices: Characteristics and performance in a clinical perspective—A review. Drug Deliv. Transl. Res. 2013, 3, 42–62. [Google Scholar] [CrossRef]
- Keller, L.-A.; Merkel, O.; Popp, A. Intranasal drug delivery: Opportunities and toxicologic challenges during drug development. Drug Deliv. Transl. Res. 2022, 12, 735–757. [Google Scholar] [CrossRef] [PubMed]
- Illum, L. Nasal drug delivery—Possibilities, problems and solutions. J. Control. Release 2003, 87, 187–198. [Google Scholar] [CrossRef] [PubMed]
- Gizurarson, S. The effect of cilia and the mucociliary clearance on successful drug delivery. Biol. Pharm. Bull. 2015, 38, 497–506. [Google Scholar] [CrossRef] [PubMed]
- Mistry, A.; Stolnik, S.; Illum, L. Nanoparticles for direct nose-to-brain delivery of drugs. Int. J. Pharm. 2009, 379, 146–157. [Google Scholar] [CrossRef] [PubMed]
- Leal, J.; Smyth, H.D.C.; Ghosh, D. Physicochemical properties of mucus and their impact on transmucosal drug delivery. Int. J. Pharm. 2017, 532, 555–572. [Google Scholar] [CrossRef]
- Proctor, D.F. The upper airways. I. Nasal physiology and defense of the lungs. Am. Rev. Respir. Dis. 1977, 115, 97–129. [Google Scholar]
- Grassin-Delyle, S.; Buenestado, A.; Naline, E.; Faisy, C.; Blouquit-Laye, S.; Couderc, L.J.; Le Guen, M.; Fischler, M.; Devillier, P. Intranasal drug delivery: An efficient and non-invasive route for systemic administration: Focus on opioids. Pharmacol. Ther. 2012, 134, 366–379. [Google Scholar] [CrossRef]
- Arora, P.; Sharma, S.; Garg, S. Permeability issues in nasal drug delivery. Drug Discov. Today 2002, 7, 967–975. [Google Scholar] [CrossRef]
- Karavasili, C.; Bouropoulos, N.; Sygellou, L.; Amanatiadou, E.P.; Vizirianakis, I.S.; Fatouros, D.G. PLGA/DPPC/trimethylchitosan spray-dried microparticles for the nasal delivery of ropinirole hydrochloride: In vitro, ex vivo and cytocompatibility assessment. Mater. Sci. Eng. C Mater. Biol. Appl. 2016, 59, 1053–1062. [Google Scholar] [CrossRef]
- Vector Laboratories Inc. Lectins and Glycobiology Brochure 2. Available online: https://vectorlabs.com/media/docs/brochures/LectinBrochure2.pdf (accessed on 8 March 2022).
- Cummings, R.D.; Darvill, A.G.; Etzler, M.E.; Hahn, M.G. Glycan-Recognizing Probes as Tools. In Essentials of Glycobiology, 3rd ed.; Varki, A., Cummings, R.D., Esko, J.D., Stanley, P., Hart, G.W., Aebi, M., Darvill, A.G., Kinoshita, T., Packer, N.H., Prestegard, J.H., et al., Eds.; Cold Spring Harbor Laboratory Press: Cold Spring Harbor, NY, USA, 2017; Chapter 48; pp. 611–625. [Google Scholar]
- Høyer, P.E.; Kirkeby, S. The impact of fixatives on the binding of lectins to N-acetyl-glucosamine residues of human syncytiotrophoblast: A quantitative histochemical study. J. Histochem. Cytochem. 1996, 44, 855–863. [Google Scholar] [CrossRef]
- Rittman, B.R.; Mackenzie, I.C. Effects of histological processing on lectin binding patterns in oral mucosa and skin. Histochem. J. 1983, 15, 467–474. [Google Scholar] [CrossRef] [PubMed]
- Allison, R.T. The effects of various fixatives on subsequent lectin binding to tissue sections. Histochem. J. 1987, 19, 65–74. [Google Scholar] [CrossRef] [PubMed]
- Cone, R.A. Barrier properties of mucus. Adv. Drug Deliv. Rev. 2009, 61, 75–85. [Google Scholar] [CrossRef]
- Mistry, A.; Glud, S.Z.; Kjems, J.; Randel, J.; Howard, K.A.; Stolnik, S.; Illum, L. Effect of physicochemical properties on intranasal nanoparticle transit into murine olfactory epithelium. J. Drug Target. 2009, 17, 543–552. [Google Scholar] [CrossRef]
- Clementino, A.R.; Pellegrini, G.; Banella, S.; Colombo, G.; Cantù, L.; Sonvico, F.; Del Favero, E. Structure and Fate of Nanoparticles Designed for the Nasal Delivery of Poorly Soluble Drugs. Mol. Pharm. 2021, 18, 3132–3146. [Google Scholar] [CrossRef]
- Berger, G.; Kogan, T.; Skutelsky, E.; Ophi, D. Glycoconjugate Expression in Normal Human Inferior Turbinate Mucosa: A Lectin Histochemical Study. Am. J. Rhinol. 2005, 19, 97–103. [Google Scholar] [CrossRef]
- Gabor, F.; Bogner, E.; Weissenboeck, A.; Wirth, M. The lectin–cell interaction and its implications to intestinal lectin-mediated drug delivery. Adv. Drug Deliv. Rev. 2004, 56, 459–480. [Google Scholar] [CrossRef] [PubMed]
- Wirth, M.; Kneuer, C.; Lehr, C.M.; Gabor, F. Lectin-mediated Drug Delivery: Discrimination Between Cytoadhesion and Cytoinvasion and Evidence for Lysosomal Accumulation of Wheat Germ Agglutinin in the Caco-2 Model. J. Drug Target. 2002, 10, 439–448. [Google Scholar] [CrossRef]
- Gao, X.; Tao, W.; Lu, W.; Zhang, Q.; Zhang, Y.; Jiang, X.; Fu, S. Lectin-conjugated PEG–PLA nanoparticles: Preparation and brain delivery after intranasal administration. Biomaterials 2006, 27, 3482–3490. [Google Scholar] [CrossRef]
- Fröhlich, E. Non-Cellular Layers of the Respiratory Tract: Protection against Pathogens and Target for Drug Delivery. Pharmaceutics 2022, 14, 992. [Google Scholar] [CrossRef]
- Ali, M.S.; Pearson, J.P. Upper airway mucin gene expression: A review. Laryngoscope 2007, 117, 932–938. [Google Scholar] [CrossRef] [PubMed]
- Bansil, R.; Turner, B.S. Mucin structure, aggregation, physiological functions and biomedical applications. Curr. Opin. Colloid Interface Sci. 2006, 11, 164–170. [Google Scholar] [CrossRef]

| Lectin | Source | Molecular Weight 1 (kDa) | Binding Motif 2 | Molar F/P Ratio 3 |
|---|---|---|---|---|
| WGA | Triticum vulgare (wheat germ) | 36 |
| 3.4 |
| LCA | Lens culinaris (lentil) | 50 |
| 3.5 |
| UEA I | Ulex europaeus (gorse) | 63 |
| 4.0 |
| GNL | Galanthus nivalis (snowdrop) | 50 |
| 4.0 |
| STL | Solanum tuberosum (potato) | 100 |
| 3.0 |
| PNA | Arachis hypogaea (peanut) | 110 |
| 4.2 |
Disclaimer/Publisher’s Note: The statements, opinions and data contained in all publications are solely those of the individual author(s) and contributor(s) and not of MDPI and/or the editor(s). MDPI and/or the editor(s) disclaim responsibility for any injury to people or property resulting from any ideas, methods, instructions or products referred to in the content. |
© 2023 by the authors. Licensee MDPI, Basel, Switzerland. This article is an open access article distributed under the terms and conditions of the Creative Commons Attribution (CC BY) license (https://creativecommons.org/licenses/by/4.0/).
Share and Cite
Gausterer, J.C.; Schlager, M.; Ahmadi, N.; Nieratschker, M.; Dahm, V.; Wirth, M.; Arnoldner, C.; Honeder, C.; Gabor, F. A Novel Preparation Technique for Human Nasal Respiratory Mucosa to Disclose Its Glycosylation Pattern for Bioadhesive Drug Delivery. Pharmaceutics 2023, 15, 973. https://doi.org/10.3390/pharmaceutics15030973
Gausterer JC, Schlager M, Ahmadi N, Nieratschker M, Dahm V, Wirth M, Arnoldner C, Honeder C, Gabor F. A Novel Preparation Technique for Human Nasal Respiratory Mucosa to Disclose Its Glycosylation Pattern for Bioadhesive Drug Delivery. Pharmaceutics. 2023; 15(3):973. https://doi.org/10.3390/pharmaceutics15030973
Chicago/Turabian StyleGausterer, Julia Clara, Michael Schlager, Navid Ahmadi, Michael Nieratschker, Valerie Dahm, Michael Wirth, Christoph Arnoldner, Clemens Honeder, and Franz Gabor. 2023. "A Novel Preparation Technique for Human Nasal Respiratory Mucosa to Disclose Its Glycosylation Pattern for Bioadhesive Drug Delivery" Pharmaceutics 15, no. 3: 973. https://doi.org/10.3390/pharmaceutics15030973
APA StyleGausterer, J. C., Schlager, M., Ahmadi, N., Nieratschker, M., Dahm, V., Wirth, M., Arnoldner, C., Honeder, C., & Gabor, F. (2023). A Novel Preparation Technique for Human Nasal Respiratory Mucosa to Disclose Its Glycosylation Pattern for Bioadhesive Drug Delivery. Pharmaceutics, 15(3), 973. https://doi.org/10.3390/pharmaceutics15030973

